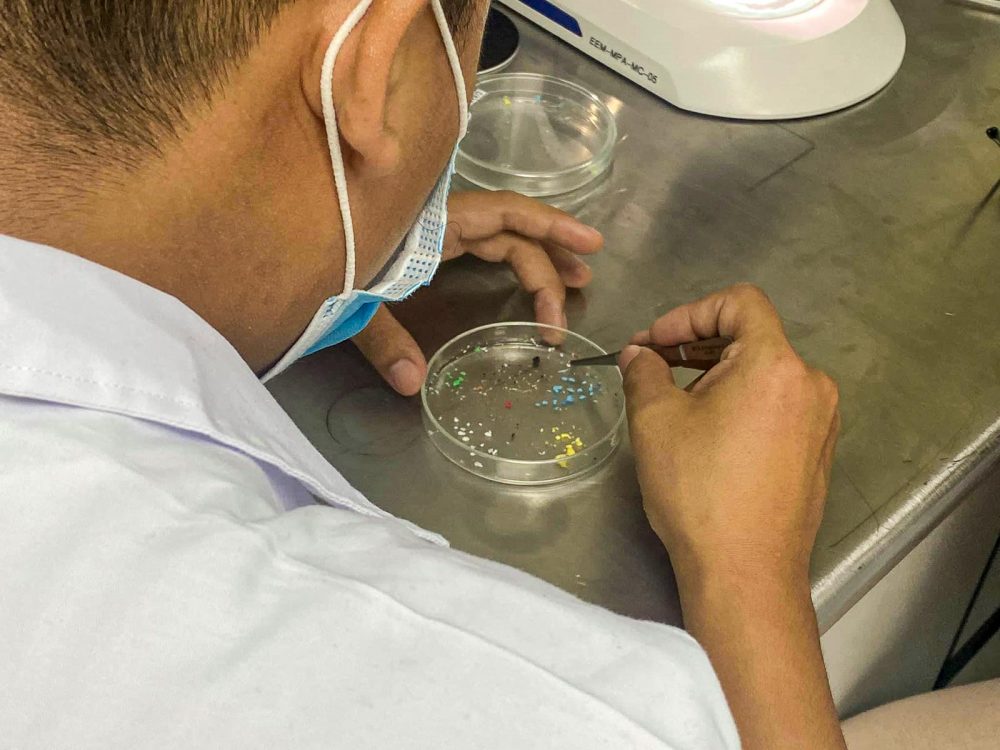

ปัญหาขยะพลาสติกทางทะเล เกิดขึ้นได้อย่างไร เรามีส่วนก่อปัญหานี้แค่ไหน ร้ายแรงและส่งผลกระทบต่อเราหรือไม่ และมีแนวทางป้องกันแก้ไขอย่างไร ท่านผู้อ่านเคยสงสัยกันบ้างไหม? วันนี้ room หาคำตอบมาให้แล้ว
ปัญหาขยะพลาสติกทางทะเล เป็นอีกปัญหาสิ่งแวดล้อมที่เริ่มมีการตื่นตัวมากขึ้นในปัจจุบัน ไม่ว่าจะเพราะภาพข่าวของสัตว์ทะเลที่ได้รับผลกระทบจากขยะพลาสติกซึ่งย่อยสลายยากเหล่านี้ ภาพของเกาะขยะกลางทะเลขนาดใหญ่เท่าประเทศย่อม ๆ หรือแม้แต่ไมโครพลาสติกที่กลับมาสู่คนเมืองในรูปการปนเปื้อนทางอาหาร แต่ปัญหาเหล่านี้มีสาเหตุมาจากที่ใด เรามีส่วนกับการก่อปัญหานี้มากแค่ไหน และเราจะมีแนวทางในการป้องกัน และแก้ไขได้ปัญหานี้ได้อย่างไร วันนี้ room จึงได้มาพูดคุยกับผู้เชี่ยวชาญด้านนี้โดยตรงอย่าง ศ.ดร.ธรรมรัตน์ คุตตะเทพ หัวหน้า หัวหน้าสาขาวิชาการจัดการขยะพลาสติกในทะเล (Marine Plastics Abatement หรือ MPA) คณะสิ่งแวดล้อม ทรัพยากร และการพัฒนา (SERD) สถาบันเทคโนโลยีแห่งเอเชีย (AIT) มาอธิบายและไขข้อสงสัยให้กับเราอย่างหมดเปลือก


ปัญหาขยะพาสติกทางทะเล ปัญหาที่ใกล้ตัวกว่าที่คิด
room : ปัญหาขยะพาสติกทางทะเล บางครั้งอาจจะดูเป็นเรื่องไกลตัว แท้จริงแล้วเกี่ยวข้องกับใครบ้าง?
ศ.ดร.ธรรมรัตน์ : “จริง ๆ ปัญหาขยะทางทะเล ไม่ได้เกิดขึ้นจากกิจกรรมในทะเลอย่างเดียว มีการศึกษาว่า 80% นั้นมาจากขยะบนบกแทบทั้งสิ้น ซึ่งเป็นผลพวงมาจากปัญหาขยะทางบกก่อนแล้วไหลลงสู่ทะเล โดยเฉพาะในพื้นที่ประเทศในทวีปเอเชียนั้นเป็นประเทศที่ปล่อยขยะลงทะเลมากที่สุดในโลก”
room : เกิดผลกระทบต่อเราอย่างไร?
ศ.ดร.ธรรมรัตน์ : “ปัญหาที่เห็นได้ชัดก็คือการส่งผลกระทบต่อสัตว์น้ำทั่วโลก ทั้งทางตรงที่สัตว์กินเข้าไปแล้วเสียชีวิต หรือไมโครพลาสติกที่เริ่มเข้ามาปนเปื้อนในห่วงโซ่อาหาร ซึ่งเป็นปัญหาที่ใหญ่ แต่ยังได้รับความสนใจที่น้อยอยู่ ซึ่งถ้าหากเรามีการจัดการขยะที่ดีปัญหานี้ก็น่าจะดีขึ้น ไม่เพียงแต่สัตว์น้ำ แต่ไมโครพลาสติกที่ไปปนเปื้อนยังปะการังทำให้เกิดการฟอกขาว ทำให้เกิดปัญหาโลกร้อนตามมาอีก สิ่งเหล่านี้ส่งผลกระทบกันหมด แล้วสุดท้ายปรากฏการณ์และการปนเปื้อนต่าง ๆ ก็จะส่งผลกระทบกลับมาสู่เมือง”

รู้จัก Ocean Plastic Trash ให้มากกว่าเดิม
room : ในปัจจุบัน ขยะประเภทใดที่สร้างปัญหาให้กับท้องทะเลมากที่สุด?
ศ.ดร.ธรรมรัตน์ : “ในมุมมองของผมนั้นขยะที่เป็นปัญหาที่สุด คือขยะที่รีไซเคิลไม่ได้ หรือ Non Recyclable Plastic เพราะอย่างที่ได้บอกว่าไม่ใช่ขยะพลาสติกทุกอย่างจะนำมารีไซเคิลได้ เช่น ซองถุงขนม ที่มีทั้งพลาสติกและโลหะหนักอยู่ด้วยกัน ก็ทำให้นำมาจัดการได้อย่างยากลำบาก ซึ่งจริง ๆ ก็เป็นปัญหาแบบนี้ทั่วโลก การจัดการที่ปลายทางเพื่อนำไปเป็นพลังงานก็เรื่องหนึ่ง แต่สิ่งที่จะแก้ไขได้จริง ๆ คือการจัดการคัดแยก และจัดเก็บที่ถูกต้องตั้งแต่ต้นทาง”
room : สิ่งที่ถูกดำเนินการในการจัดการในปัจจุบันทำอย่างไร
ศ.ดร.ธรรมรัตน์ : “การจัดการที่ดีต้องเริ่มตั้งแต่การจัดเก็บ การจัดการความสกปรกจากต้นทาง เพื่อให้การรีไซเคิลเป็นไปได้โดยสะดวกมากขึ้น เพราะถ้าขยะมีความเปื้อนมา เช่น ขยะที่เป็นบรรจุภัณฑ์อาหาร โรงงานก็ไม่อยากรับซื้อ เพราะต้องไปทำความสะอาดก่อนการจัดการ สุดท้ายก็จะไปจบที่การนำไปถมที่เป็น Landfill แต่วิธีการนี้ก็จะทำให้เกิดไมโครพลาสติกลงสู่แหล่งน้ำได้อยู่ดี
“อีกแนวทางหนึ่งที่กำลังเกิดขึ้น คือการที่นักออกแบบเริ่มแยกประเภทของพลาสติกออกจากกันไม่ทำเป็น Composite Plastic เพื่อให้การจัดการหลังหมดสภาพการใช้งานเป็นไปได้ง่ายขึ้น สามารถแยกส่วนเพื่อนำไปรีไซเคิลได้ทันที ซึ่งเป็นตัวอย่างที่ดีที่ทำให้เห็นการมองปัญหาตั้งแต่ต้นทางจนถึงปลายทาง”
room : แสดงว่า “ปัญหาขยะพลาสติกทางทะเล” นั้นสามารถมีการร่วมแก้ไขปัญหาได้ แม้ว่าจะเป็นคนที่อยู่ในเมือง ไม่จำเป็นต้องลงพื้นที่ไปยังท้องทะเลด้วยซ้ำ?
ศ.ดร.ธรรมรัตน์ : “เพราะทุก ๆ คนสามารถมีส่วนช่วยตรงนี้ได้ทั้งหมด ยกตัวอย่างคนกรุงเทพฯ ถ้ามีการจัดการที่ดีพอ เปลี่ยนจากการนำขยะไปยังบ่อจัดเก็บเป็นการทำเตาเผาที่มีประสิทธิภาพอย่างในประเทศญี่ปุ่น ขยะที่จะหลุดลอดลงไปยังแหล่งน้ำก็จะน้อยลง แบบนี้ก็เป็นแนวทางหนึ่งที่สามารถทำให้เกิดขึ้นได้จริง แต่ก็ยังเป็นแผนการอยู่มานานมาก แล้วก็ยังคงศึกษาผลกระทบและการลงทุนอยู่ นอกจากจะสามารถจัดการกับขยะได้แล้ว ยังอาจเวียนกลับมาเป็นพลังงานได้อีกด้วย”
ความตระหนักถึงปัญหา = จุดเริ่มของการแก้ไข
room : ในไทยถือว่าทำได้ดีหรือยังกับการจัดการขยะเหล่านี้
ศ.ดร.ธรรมรัตน์ : “ไทยเราก็ถือว่ามีพัฒนาการและมาตรการที่ดีขึ้นมาเรื่อย ๆ แต่ก็ยังต้องมีการพัฒนาและรณรงค์เรื่องการคัดแยกขยะอีกมากพอสมควร ซึ่งสิ่งเหล่านี้ยังมีคอขวดของการพัฒนาอยู่บ้างหรือยัง”
room : กับคำตอบว่า “ดีขึ้นมาเรื่อย ๆ” นั้นแสดงว่ามีจุดเปลี่ยนบางอย่างของการพัฒนาอยู่
ศ.ดร.ธรรมรัตน์ : “เพราะประชาชนเริ่มมีการตระหนักรู้มากขึ้น ทำให้เกิด Social Pressure ขึ้นมาเยอะขึ้น ทำให้สังคมเริ่มรับรู้ว่าต้องมีการรณรงค์ และการจัดการตรงนี้ให้มากขึ้น ซึ่งเกิดจากปรากฏการณ์ที่ชัดขึ้นเรื่อย ๆ ของปัญหา ทั้งสัตว์น้ำเสียชีวิต หรือไมโครพลาสติก สิ่งเหล่านี้ทำให้เห็นว่าปัญหานี้ไม่ใช่เรื่องไกลตัวอีกต่อไป ซึ่ง 4-5 ปี ที่ผ่านมา เริ่มมีองค์กรใหม่ ๆ มีวิธีการใหม่ ๆ มีการส่งเสริมทั้งจากภาครัฐและเอกชนมากขึ้น”
room : หรือจริง ๆ แล้วการเลิกใช้พลาสติกจะเป็นคำตอบ?
ศ.ดร.ธรรมรัตน์ : “จะพูดแบบนั้นก็ไม่ถูก เพราะหากมีการจัดการพลาสติกที่ถูกต้อง พลาสติกนั้นก่อ Carbon Emission น้อยกว่าถุงผ้าเสียอีกหากเปรียบเทียบพลังงานในการผลิต แต่ปัญหาคือเมื่อใช้เสร็จแล้วมันยังไม่เกิดการเวียนใช้ให้ครบวงจรเป็น Circular Economy การจัดการตรงนั้น ยังไม่คุ้มทุนสำหรับผู้ประกอบการ ณ ตอนนี้สิ่งที่ทำได้จึงเป็นการร่วมกันรณรงค์ให้มีการจัดการคัดแยกตั้งแต่ที่ครัวเรือน การนำไปรีไซเคิลก็จะง่ายขึ้น พลาสติกไม่ใช่ผู้ร้ายหากเราสร้างทัศนคติที่ดีมีการจัดการที่ถูกต้อง”
room : จะทำอย่างไรให้มูลค่าของขยะพลาสติกดีขึ้นได้? เพื่อให้คุ้มค่ากับธุรกิจของการจัดการขยะ
ศ.ดร.ธรรมรัตน์ : “การจัดการขยะตั้งแต่ซาเล็งไปจนถึงโรงงานจัดการขยะนั้น ปัจจุบันเริ่มที่จะไม่อยากรับขยะบางชนิดแล้ว เพราะว่าไม่คุ้มค่าด้วยราคาที่น้อย ในส่วนตรงนี้นั้นหากจะทำให้บุคลากรเหล่านี้ยังคงทำงานอยู่ได้ การสร้างให้ขยะมีมูลค่ามากขึ้น จึงเป็นเรื่องสำคัญ วิธีการหนึ่งที่ผมอยากแนะนำ คือการลดการนำเข้าขยะ เพราะถ้ามีการนำเข้าขยะอยู่แบบนี้ ขยะภายในประเทศก็จะมีราคาที่ต่ำลงทำให้ผู้ที่ทำงานในสายงานเหล่านี้ ได้ผลตอบแทนที่น้อยเกินกว่าจะทำได้ หากมีการลดการนำเข้าขยะ หรือยกเลิกไป การจัดการขยะก็จะมีมูลค่าและพัฒนาขึ้นได้ เพราะโรงงานต่าง ๆ ก็ยังต้องการขยะรีไซเคิลเข้าไปใช้ในกระบวนการผลิตอยู่แล้ว ยกตัวอย่างโรงงานผ้าที่ใช้ขวด PET ไปรีไซเคิลเป็นเส้นใย ขวด PET ในไทยนั้น ก็มีความปนเปื้อนสกปรกอยู่ แต่พอเค้าใช้ขยะขวด PET ที่นำเข้ามาจากไต้หวัน และเกาหลี มันสะอาดกว่า เขาก็เลือกไปใช้แบบนั้นมากกว่าเพราะใช้งานได้ทันทีและมีคุณภาพ”
room : ปัจจุบัน สังคมตระหนัก และรับรู้ถึงปัญหานี้ดีแค่ไหน
ศ.ดร.ธรรมรัตน์ : “ณ ปัจจุบัน ก็ยังเรียกว่ามีความตระหนักที่น้อยเกินไปบ้าง ส่วนหนึ่งเพราะคิดกันว่ามันเป็นปัญหาทางทะเลเพียงเท่านั้น ก็จะรับรู้อยู่เพียงผู้ที่สนใจปรากฏการณ์ทางทะเล แต่ในความเป็นจริงแล้วขยะเหล่านี้มาจากบนบก ไม่ใช่แค่เมืองที่อยู่บนชายฝั่ง เพราะขยะเหล่านี้มันไม่ย่อยสลาย ขยะจากเมืองเมื่อลงสู่แหล่งน้ำก็จะไหลลงเรื่อย ๆ จนสุดท้ายก็ลงสู่ทะเล เพราะฉะนั้นการจัดการที่ดีคือการจัดการตั้งแต่ต้นทาง ไม่ใช่การโฟกัสที่ปลายทางว่า ขยะทางทะเลต้องมาจากคนริมทะเล หรือการประมงเพียงเท่านั้น ส่วนนั้นเป็นเพียงแค่ส่วนหนึ่งของปัญหาทั้งหมดเท่านั้น ซึ่งอย่างที่ AIT ก็มีประเทศที่ไม่ได้อยู่ติดทะเลก็มาเรียนเหมือนกัน เช่น เนปาล หรือลาว ประเทศเหล่านี้ก็มีส่วนของปัญหาเหล่านี้เช่นเดียวกัน ถ้าไม่มีการจัดการที่ดีพอ”
room : นอกจากความตระหนักรู้ถึงปัญหาแล้ว คิดว่ามีสิ่งใดอีกบ้างที่จะช่วยให้ปัญหานี้ดีขึ้นได้
ศ.ดร.ธรรมรัตน์ : “ความเข้าใจและตระหนักถึงปัญหาก็เป็นส่วนหนึ่ง แต่ส่วนสำคัญคือการให้ความสำคัญ และสนับสนุนผลิตภัณฑ์ที่ตั้งใจแก้ปัญหานี้ เราควรสร้างความนิยมที่ดีให้เกิดขึ้น เช่น เสื้อผ้าที่ใช้กันอยู่นั้นหากมีการผสมเส้นใยรีไซเคิลลงไปสัก 20% ก็ควรจะได้รับความสนใจให้เกิดเป็นกระแสที่สนับสนุนมากขึ้น ถ้าทำได้ระบบเศรฐกิจหมุนเวียนหรือ Circular Economy เหล่านี้ก็จะเกิดขึ้นได้ในที่สุด การพัฒนาไปของการแปลงขยะให้กลับมาเป็นผลิตภัณฑ์ก็จะได้รับการพัฒนาตามไปด้วย ซึ่งจะส่งผลกลับมาที่การจัดการต้นทางไปทั้งองคาพยพ”

ECO DESIGN งานออกแบบที่ช่วยขับดันแนวคิดที่ดีสู่ความยั่งยืน
room : ในแง่ของแนวทางแก้ไขปัญหา เราจะสามารถใช้งานออกแบบช่วยแก้ไขปัญหานี้ได้หรือไม่?
ศ.ดร.ธรรมรัตน์ : “ในแง่ของงานออกแบบ ผมคิดว่ายังไม่ใช่สิ่งรับประกันในการแก้ไขภาพใหญ่ของปัญหานี้ได้ อย่างการไปเก็บขยะมาทำเป็นงานออกแบบ ต้องยอมรับว่าถ้าเทียบกับจำนวนแล้วน้อยมาก แต่ว่างานออกแบบที่ดีนั้นสามารถสร้างความตระหนักรู้ให้กับผู้คนได้ เพราะขยะพลาสติกก็ไม่ใช่ว่าจะสามารถนำมารีไซเคิลได้หมด บางชนิดก็ไม่ได้ แต่ก็เป็นแนวทางที่ดีให้กับการหาทางออกให้กับผู้ที่สนใจได้ สิ่งสำคัญคือในการจัดการกับขยะพลาสติกเหล่านี้ เราควรทำความเข้าใจแนวคิดที่จะทำให้การจัดการขยะพลาสติกกลายเป็น “ธุรกิจอย่างยั่งยืน” ได้อย่างไรตรงนี้แหละที่สำคัญ ยกตัวอย่าง Freitag ที่นำผ้าใบเก่ามาใช้จนกลายเป็นธุรกิจที่ใหญ่ และมีการแข่งขัน มูลค่าเหล่านั้นจะไปช่วยผลักดันให้การจัดการขยะเป็นรูปธรรมได้มากขึ้น แต่ขยะเหล่านี้ก็ไม่สามารถนำมารีไซเคิลได้ทั้งหมด ก็ต้องมีการทำความเข้าใจว่า จริง ๆ แล้วขยะพลาสติกเหล่านี้มีที่มาที่ไปอย่างไร มีกี่ประเภท และกลับไปเป็นส่วนหนึ่งของระบบอุตสาหกรรมของตลาดได้อย่างไร”
Marine Plastics Abatement ภาควิชาที่สร้างมาเพื่อการแก้ปัญหาที่ยั่งยืน นั่นคือการสร้างกลไกทางเศรษฐศาสตร์ของขยะ plastic เพื่อลดการนำเข้าและเกิด supply chain ในประเทศ
room : ในส่วนของภาควิชานี้ มุ่งเน้นในพันธกิจด้านใดต่อปัญหานี้ครับ?
ศ.ดร.ธรรมรัตน์ : “เดิมที่ AIT มีการเรียนการสอนเกี่ยวกับการจัดการสิ่งแวดล้อมมาโดยตลอดอยู่แล้ว ซึ่งครอบคลุมตั้งแต่ต้นทางจนปลายทาง จนปี 2019 ทาง AIT ก็เริ่มเปิดภาควิชาการจัดการขยะ พลาสติกในทะเล (Marine Plastics Abatement หรือ MPA) โดยการปรับปรุงจากบุคลากรที่เชี่ยวชาญด้านการจัดการขยะพลาสติก ร่วมกับผู้เชี่ยวชาญจากวิทยาศาตร์ทางทะเลด้วย”
room : มีวิธีการวางหลักสูตรอย่างไร? สร้างบุคลากรเพื่อเติมเต็มในส่วนงานใด
ศ.ดร.ธรรมรัตน์ : “ในส่วนนี้คือมีการวางแผนตั้งแต่เริ่มต้นว่าจะรับใครเข้ามาเรียน โดยที่จะรับนักศึกษาที่มาจากสายวิศวกรรม และผู้ประกอบการ รวมถึง NGO ด้วย เพื่อนำเอาองค์ความรู้เหล่านี้กลับไปพัฒนาในสายงานของตัวเอง โดยที่มีเทคโนโลยีเป็นแกน แต่สามารถนำไปบูรณาการ และแลกเปลี่ยนความคิดร่วมกันระหว่างผู้เรียนได้ มีทั้งพื้นฐานเกี่ยวกับการจัดการขยะพลาสติก และได้เรียนรู้เทคโนโลยีและนวัตกรรมที่สามารถนำมาพัฒนาเพื่อแก้ไขปัญหาเหล่านี้ได้ในที่สุด แต่ส่วนที่สำคัญที่สุด คือการที่จะได้เรียนรู้ว่าเราสามารถพัฒนาการจัดการพลาสติกให้กลายเป็นธุรกิจที่ยั่งยืนได้อย่างไร ซึ่ง AIT ก็มีภาคการจัดการธุรกิจด้วย หากทำให้วิธีการเหล่านี้กลายเป็นธุรกิจได้จริงแล้ว ก็จะสามารถยังให้เกิดผลในระยะยาว ซึ่งหลักสูตรนี้จะเป็นลักษณะแบบปีเดียวจบ เพื่อสร้างบุคลากรสำหรับปัญหาเหล่านี้ให้เกิดขึ้นเร็วที่สุด”
room : แสดงว่าการสร้างให้การแก้ไขปัญหาเหล่านี้กลายเป็นธุรกิจได้อาจจะเป็นคำตอบของการแก้ไขปัญหาในระยะยาว
ศ.ดร.ธรรมรัตน์ : “อย่างที่บอกว่า Circular Economy คือทางออกหนึ่งของปัญหาเหล่านี้ การสร้างความเข้าใจเพียงอย่างเดียวไม่สามารถจูงใจให้เกิดการลงทุนในการจัดการเหล่านี้ได้มากพอ หากสิ่งเหล่านี้กลายเป็นธุรกิจที่มีมูลค่าแล้ว การแก้ไขปัญหาต่าง ๆ ก็จะเป็นไปได้มากขึ้น ทั้งในมุมของการเป็นผู้ประกอบการเอง หรือในมุมที่จะมีผู้ประกอบการมาร่วมลงทุน”
room : สุดท้ายนี้หลังจากเปิดหลักสูตรมาได้เกือบปี มีเสียงตอบรับและแผนการในอนาคตอันใกล้อย่างไรต่อไป?
ศ.ดร.ธรรมรัตน์ : “มีความท้าทายเยอะ ทั้งประสบการณ์ที่แตกต่างกัน ซึ่งมีพื้นที่ที่แตกต่างกันเช่นกัน แต่เมื่อได้มาเรียนด้วยกันแล้ว การแลกเปลี่ยนประสบการณ์ได้เปิดความคิดให้เห็นความเป็นไปได้ที่มากขึ้น ได้มองปัญหาจากหลายมุมมองมากขึ้น ทำให้ผลลัพธ์ที่เกิดขึ้นมีมุมมองที่น่าสนใจ และไม่ใช่แค่เพียงเรื่องทางวิชาการเพียงเท่านั้น แต่กลายเป็นวิธีการที่สามารถนำไปใช้ได้จริงในทางปฏิบัติ ซึ่งในอนาคตอาจจะเริ่มพัฒนาหลักสูตรในปัญหาที่เกี่ยวเนื่องต่อไปอีก เช่น River Plastics Abatement หรือการจัดการขยะพลาสติกในแม่น้ำและลำคลอง เพื่อให้การแก้ไขปัญหาเหล่านี้ครอบคลุมมากขึ้น และทาง AIT ก็มีหลักสูตรที่หลากหลายน่าสนใจ และตอบโจทย์กับภาคสังคมมากขึ้น โดยที่มีหลักสูตรเกี่ยวกับการจัดการสิ่งแวดล้อมอยู่หลายหลักสูตรด้วยกัน เพราะอยากสร้างให้การจัดการสิ่งแวดล้อมนั้นกลายเป็นจริงได้ในภาคธุรกิจ ไม่ใช่แค่เพียงแคมเปญเพียงชั่วเวลาหนึ่ง สิ่งเหล่านี้จะกลายเป็นเทรนด์ใหม่ของโลกและกลายเป็นสิ่งสามัญต่อไปในอนาคตอันใกล้อย่างแน่นอน”







ติดต่อ สาขาวิชาการจัดการขยะพลาสติกในทะเล (Marine Plastics Abatement หรือ MPA) คณะสิ่งแวดล้อม ทรัพยากร และการพัฒนา (SERD) สถาบันเทคโนโลยีแห่งเอเชีย (AIT)
โทร. 0-2524-5440, 5407, 5642, 5646, 6165
Email : [email protected]
https://serd.ait.ac.th/
ภาพ : สถาบันเทคโนโลยีแห่งเอเชีย (AIT)
เรื่อง : Wuthikorn Sut
#BETTERISM